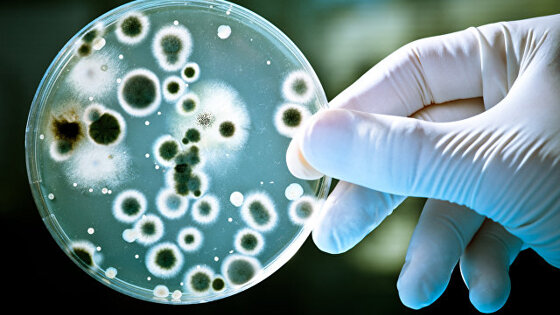

Российские и японские инфекционисты зафиксировали появление новых опасных штаммов золотистого стафилококка на территории России, завезенных из стран Ближнего Востока и Европы, часть из которых почти неуязвима для действия антибиотиков, говорится в статье, опубликованной в журнале Infection, Genetics and Evolution.
"В своей работе мы обнаружили MRSA-стафилококк у здоровых людей, и по проведенным молекулярным данным выяснилось, что эти бактерии пришли к нам из Сектора Газа. Пока они ничем нам не угрожают, но это бомба замедленного действия. Если пациент попадает в стационар с любой банальной инфекцией, то он может распространить такие нехорошие стафилококки", – рассказывает Владимир Гостев из Детского научно-клинического центра инфекционных болезней в Санкт-Петербурге.
В последние годы перед медиками все шире и острее становится проблема появления так называемых "супер-бактерий" – микробов, стойких к действию одного или нескольких антибиотиков. Среди них есть как редкие возбудители инфекций, так и очень распространенные и опасные патогены, такие как золотистый стафилококк (Staphilococcus aureus) или пневмококк (Klebsiella pneumoniae). Возникла реальная опасность того, что все антибиотики потеряют свою эффективность и медицина вернется в "темные века".
Главными "инкубаторами" таких микробов, как считают ученые сегодня, являются больницы и животноводческие фермы, где антибиотики используются для ускорения роста мясных пород скота. И на фермах, и в больницах сосредоточены большие количества и потенциальных носителей инфекции, и самих бактерий, и антибиотиков, заставляющих их эволюционировать и не дающих "обычным" бактериям вытеснить менее плодовитых супер-микробов.
Как передает пресс-служба Российского научного фонда, спонсировавшего исследования Гостева и его коллег, до настоящего времени у российских ученых не было данных по тому, как часто встречаются и как сильно распространены так называемые MRSA – штаммы золотистого стафилококка, неуязвимые для действия метициллина и ряда других антибиотиков.
Гостев и его команда решили заполнить этот пробел, изучив образцы стафилококка, собранные в 15 разных городах и регионах России, в том числе в Москве, Самаре, Перми, Ханты-Мансийске, Красноярске и Кургане. Эти пробы, как рассказывают ученые, собирались не только в медицинских учреждениях, где чаще всего встречаются колонии "неуязвимого" стафилококка, но и в ряде торговых сетей, где также могут присутствовать болезнетворные микробы.
Ученые проанализировали, в общей сложности, микрофлору примерно двух тысяч россиян, около 20% которых оказались носителями "обычного" стафилококка, который не является особой проблемой для медиков. С другой сторон, 13 сотрудников магазинов и 25 сотрудников медицинских учреждений оказались носителями MRSA-штаммов, что стало первым свидетельством их присутствия на территории России.
Помимо микробов-"беженцев" из Палестины, российские ученые обнаружили и других потенциально опасных бактерий, устойчивых к действию цефтаролина, одного из "антибиотиков последней надежды", и попавших в Россию из Германии или других стран Центральной Европы. Как заключают ученые, появление новых генетических линий MRSA требует изменения подходов к диагностике, лечению и принятию срочных мер по сдерживанию распространения стафилококковых инфекций.